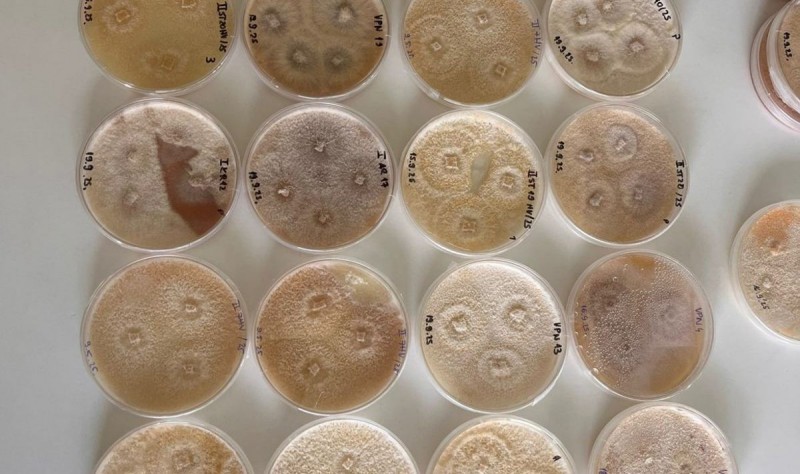

Očuvanje šuma maruna: Biološka zaštita kestena u Opatiji i Lovranu
Autor: Nikola Cvjetović 08.10.2025

Projekt zaštite maruna u potpunosti financira Centar za poljoprivredu i ruralni razvoj Primorsko-goranske županije.

Opatija - Na području Opatije i Lovrana nastavljene su jesenske akcije zaštite šuma pitomog kestena. Stručnjaci Hrvatskog šumarskog instituta, uz podršku Grada Opatije, proveli su primjenu bioloških pasti na stabla zaražena rakom kestenove kore. Cilj ove metode je zaustaviti širenje bolesti i omogućiti prirodno zacjeljivanje stabala.

Pasta, razvijena u laboratoriju Šumarskog instituta, sadrži hipovirulentne sojeve koji djeluju kao prirodni lijek za kestene, potičući oporavak stabla i smanjujući širenje infekcije putem vjetra, kiše i insekata. Ova biološka metoda smatra se ekološki održivim rješenjem koje može dugoročno pomoći u zaštiti maruna.
Projekt zaštite maruna u potpunosti financira Centar za poljoprivredu i ruralni razvoj Primorsko-goranske županije.